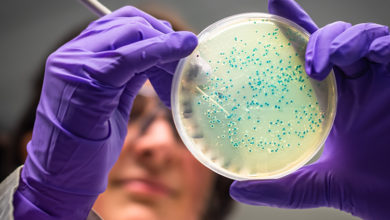

ENBIOSIS
-
Gastroenteroloji ( Mide Hastalıkları )
Huzursuz bağırsak sendromu tedavisinde %78 başarıya ulaşıldı
Türkiye’de yaşayan insanların yaklaşık %15’inin muzdarip olduğu Hassas Bağırsak Sendromu’un tedavi desteğine yönelik yapılan klinik çalışmada önemli bir başarıya imza…
Devamını Oku » -
Gebelik ( Hamilelik ) Tüp Bebek
Gebelikteki riskleri önceden tespit etmek mümkün
Dünya genelinde her yıl 15 milyon erken doğum gerçekleşiyor; erken doğum, yenidoğan ölümlerinin en yaygın nedenleri arasında yer alıyor. Bu…
Devamını Oku »